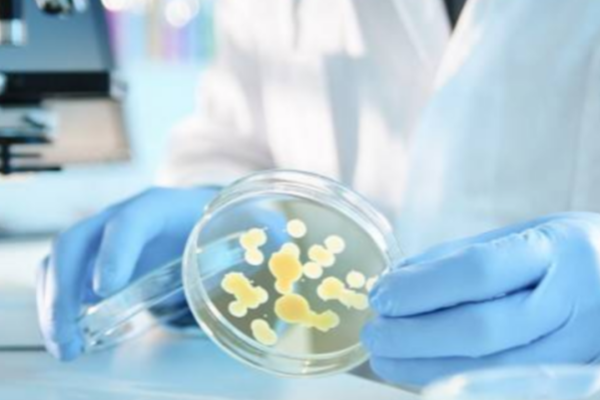

杭州大吕科技有限公司
从事仪表开发设计、生产、销售于一体的专业仪表科技企业
产品中心
工程案例
从事仪表开发设计、生产、销售于一体的专业仪表科技企业
大吕科技四大优势
杭州大吕科技有限公司是一家集研制、开发、生产、销售、服务于一体的规模专业仪表科技企业。
advantage
专注20年
04
服务优势 SERVICE ADVANTAGE
01
品牌优势 BRAND ADVANTAGE
02
产品优势 PRODUCT ADVANTAGE
03
客户优势 CUSTOMER ADVANTAGE
杭州大吕科技有限公司
公司简介
资质荣誉
公司是一家集研发、设计、生产、销售及服务于一体的综合性高新技术企业,同时也是浙江省认定的科技型企业。在智能化仪表、工程数据实时监测、能源计量管理系统等关键领域,公司凭借深厚的专业积淀,掌握了先进的核心技术,积累了独到且丰富的实践经验。
发展历程
企业文化
从事仪表开发设计、生产、销售于一体的专业仪表科技企业
关于我们
新闻资讯
从事仪表开发设计、生产、销售于一体的专业仪表科技企业
服务体系
以“需求洞察→方案设计→交付实施→运营支持→价值升级”为闭环,构建五阶段服务体系
营销网络
拥有健全的销售体系,完善的营销网络,产品远销海外众多国家和地区
服务支持
从事仪表开发设计、生产、销售于一体的专业仪表科技企业
合作伙伴
从事仪表开发设计、生产、销售于一体的专业仪表科技企业